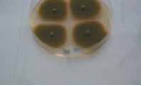
εικόνα

|
Εξάλλου, πολλοί μικροοργανισμοί όχι μόνο δεν προκαλούν ασθένειες, αλλά είναι και χρήσιμοι για τον άνθρωπο. Ένας μικροοργανισμός που εισέρχεται στον άνθρωπο και του προκαλεί ασθένεια χαρακτηρίζεται παθογόνος. Ο άνθρωπος που προσβάλλεται ονομάζεται ξενιστής. Η είσοδος του παθογόνου μικροοργανισμού σε έναν ξενιστή ονομάζεται μόλυνση. Μια ασθένεια που μπορεί να μεταδοθεί από ένα άτομο σε άλλο χαρακτηρίζεται μολυσματική. Όταν κάποιος ασθενεί, συνήθως εμφανίζει ορισμένα συμπτώματα της ασθένειας (π.χ. πυρετό, διάρροια κτλ.). Η εξέταση των συμπτωμάτων μπορεί να οδηγήσει τον γιατρό στη διάγνωση, δηλαδή στην αναγνώριση της ασθένειας. Από τη στιγμή που θα μας προσβάλει ένας μικροοργανισμός μπορεί να περάσουν ώρες, μέρες ή ακόμα και μήνες μέχρι να αρχίσουν να εμφανίζονται τα πρώτα συμπτώματα της ασθένειας. Αυτό εξαρτάται από την περίοδο επώασης του μικροοργανισμού, δηλαδή από το χρόνο που απαιτείται μεταξύ της μόλυνσης και της εμφάνισης των πρώτων συμπτωμάτων της ασθένειας.  ΒΙΟΛΟΓΙΑ ΚΑΙ... ΚΑΘΗΜΕΡΙΝΗ ΖΩΗYπάρχουν και χρήσιμα μικρόβια... Εδώ και πάρα πολλά χρόνια ο άνθρωπος έχει ανακαλύψει πολλούς τρόπους να χρησιμοποιεί τα μικρόβια σε διάφορες εφαρμογές, όπως:
 Η ΒΙΟΛΟΓΙΑ ΚΑΙ... ΟΙ ΑΛΛΕΣ
|
  Εικ. 4.2 Οι μύγες μπορεί να μεταφέρουν Συχνά ακούμε στην τηλεόραση ότι «ξέσπασε» επιδημία γρίπης. Η γρίπη είναι μια μολυσματική ασθένεια που οφείλεται σε ιό. Όταν όμως σε μια συγκεκριμένη χρονική περίοδο παρατηρηθεί μεγάλος αριθμός κρουσμάτων μιας ασθένειας, όπως, για παράδειγμα, της γρίπης, τότε λέμε ότι έχουμε επιδημία. Εάν η ασθένεια αυτή εξαπλωθεί σε πολλές χώρες, τότε έχουμε πανδημία. Για να εξαπλωθεί μια ασθένεια, πρέπει ο μικροοργανισμός που ευθύνεται γι’ αυτή να μολύνει πολλά άτομα. Yπάρχουν διάφοροι τρόποι μετάδοσης μιας ασθένειας:
Για να μπορέσουμε να καταπολεμήσουμε τις ασθένειες που προκαλούν οι παθογόνοι μικροοργανισμοί, είναι σημαντικό να |
||||||||||||||||
|
έχουμε μελετήσει τον κύκλο της ζωής τους. Έτσι, μπορούμε να γνωρίζουμε τους τρόπους με τους οποίους μεταδίδονται στον άνθρωπο και τους μηχανισμούς με τους οποίους αναπαράγονται. Οι γνώσεις αυτές μας επιτρέπουν όχι μόνο να καταπολεμήσουμε πολλές ασθένειες (θεραπεία), αλλά, το κυριότερο, να ανακαλύψουμε τρόπους για να τις αποφύγουμε (πρόληψη). Για να κατανοήσουμε τον τρόπο με τον οποίο κάθε ομάδα μικροοργανισμών μπορεί να μολύνει και να προκαλέσει ασθένεια στον άνθρωπο, θα μελετήσουμε ορισμένα παραδείγματα.   Βακτήρια: Σε αντίθεση με τη γενική πεποίθηση, τα περισσότερα βακτήρια είναι είτε χρήσιμα είτε αβλαβή για τον οργανισμό μας. Ορισμένα, μάλιστα, υπάρχουν φυσιολογικά στο σώμα μας, όπως αυτά που φιλοξενούνται στο παχύ έντερο. Τα βακτήρια αυτά όχι μόνο δεν μας βλάπτουν, αλλά μας είναι απαραίτητα, αφού παράγουν τη βιταμίνη K, η οποία βοηθά στην πήξη του αίματος. Όσα βακτήρια μας βλάπτουν, το κάνουν ουσιαστικά με δύο τρόπους:
Ιοί: Οι ιοί αποτελούν μια ασυνήθιστη περίπτωση οργάνωσης της έμβιας ύλης. Συχνά αποτελούν αντικείμενο διαφωνίας μεταξύ των επιστημόνων. Ορισμένοι δεν τους θεωρούν οργανισμούς, επειδή οι ιοί δεν εκδηλώνουν αυτόνομα τις λειτουργίες της ζωής (π.χ. αναπαραγωγή, μεταβολισμό κ.ά.), αλλά μόνο όταν παρασιτούν στα κύτταρα άλλου οργανισμού. Οι ιοί δηλαδή πολλαπλασιάζονται και συνθέτουν τα συστατικά τους μόνο όταν χρησιμοποιούν τα υλικά και τους μηχανισμούς των κυττάρων του οργανισμού-ξενιστή. Το γεγονός αυτό όμως διαταράσσει την ομαλή λειτουργία των κυττάρων και κατά συνέπεια ολόκληρου του οργανισμού. Ένας ιός μπορεί να βρίσκεται σε «λανθάνουσα κατάσταση» μέσα στο κύτταρο, δηλαδή δεν παράγονται νέοι ιοί. Τότε ο οργανισμός που έχει προσβληθεί από αυτόν δεν εκδηλώνει κανένα σύμπτωμα. Ωστόσο, κάποια στιγμή ο ιός μπορεί να ενεργοποιηθεί και να πολλαπλασιαστεί. Οι νέοι ιοί που θα προκύψουν θα προσβάλουν κι άλλα κύτταρα, προκαλώντας συχνά σοβαρές ασθένειες, τις ιώσεις. Χαρακτηριστική και ιδιαίτερα συνηθισμένη ίωση είναι το κοινό κρυολόγημα. |
|
Ας σκεφτούμε
Στην περίπτωση των ιώσεων, ξενιστή ονομάζουμε τον οργανισμό (ή και το κύτταρο) που έχει προσβληθεί από έναν ιό. Ο ιός πολλαπλασιάζεται χρησιμοποιώντας τους μηχανισμούς και τα υλικά που του «παραχωρεί» ο ξενιστής. Η ρίζα της λέξης «ξενιστής» είναι ελληνική και σημαίνει αυτόν που παρέχει φιλοξενία, τον οικοδεσπότη. Πιστεύετε ότι πρόκειται πραγματικά για φιλοξενία;
Εικ. 4.3 Καλλιέργεια μυκήτων. Μύκητες: Αρκετές είναι και οι ασθένειες που οφείλονται σε μύκητες, με περισσότερο γνωστές τις ασθένειες του δέρματος (δερματικές μυκητιάσεις). Επειδή οι ασθένειες αυτές μεταδίδονται συνήθως μέσω της επαφής με μολυσμένα αντικείμενα, είναι σκόπιμο να χρησιμοποιούμε δικές μας πετσέτες, χτένες κτλ. Πρωτόζωα: Λίγα είναι τα πρωτόζωα που προσβάλλουν τον άνθρωπο προκαλώντας του σοβαρές ασθένειες. Ένα από αυτά είναι το πλασμώδιο, που προκαλεί την ελονοσία.  ΒΙΟΛΟΓΙΑ ΚΑΙ... ΑΛΛΗ ΒΙΟΛΟΓΙΑΠώς θα θέλατε το κρέας σας ψημένο; Η σαλμονέλα είναι μια συνηθισμένη αιτία τροφικής δηλητηρίασης που οφείλεται σε βακτήριο. Το βακτήριο σαλμονέλα ζει στο έντερο κάποιων ζώων (π.χ. κοτόπουλα) χωρίς να τους προκαλεί ασθένεια. Αν όμως ένας άνθρωπος πιει γάλα ή φάει κρέας ή αυγά που είναι μολυσμένα με τη σαλμονέλα, τότε θα εμφανίσει συμπτώματα σαλμονέλωσης, δηλαδή διάρροια, εμετούς, κοιλιακό πόνο και πυρετό. Τα συμπτώματα εμφανίζονται περίπου 12 με 24 ώρες μετά την πρόσληψη της μολυσμένης τροφής. Συνήθως δεν απειλείται σοβαρά η υγεία του ατόμου, εκτός και αν ο ασθενής είναι πολύ μικρής ή πολύ μεγάλης ηλικίας. Οι σαλμονέλες καταστρέφονται σε υψηλή θερμοκρασία και γι’ αυτό είναι σκόπιμο το κρέας να ψήνεται καλά και το γάλα να παστεριώνεται. Προσοχή επίσης πρέπει να δίνεται στη μεταφορά και στη φύλαξη του ωμού κρέατος. Το ωμό κρέας δεν πρέπει να έρχεται σε επαφή με άλλα τρόφιμα, και ιδιαίτερα με όσα καταναλώνονται χωρίς να μαγειρευτούν, π.χ. ωμές σαλάτες.  ΒΙΟΛΟΓΙΑ ΚΑΙ... ΑΛΛΗ ΒΙΟΛΟΓΙΑΚινδυνεύω αν δανειστώ την πετσέτα σου; Οι περισσότερες από τις ασθένειες του δέρματος οφείλονται σε μύκητες. Ένας από αυτούς (Candida albicans) προσβάλλει την κεράτινη στιβάδα του δέρματος και δημιουργεί αντιαισθητικές κηλίδες. Όλα τα είδη μυκητιάσεων είναι πολύ μεταδοτικά. Συνήθως μεταδίδονται με τη χρήση αντικειμένων, όπως πετσέτες και παπούτσια, ενός μολυσμένου ατόμου. Επειδή η ανάπτυξη των μυκήτων ευνοείται σε συνθήκες υγρασίας και ζέστης, πρέπει:
|
α. Οι άνθρωποι πριν από τον 19ο αιώνα γνώριζαν ότι αρκετές από τις ασθένειες που τους πρόσβαλλαν οφείλονταν σε μικροοργανισμούς. β. Όλοι οι μικροοργανισμοί δεν είναι παθογόνοι. γ. Η επώαση μιας ασθένειας μπορεί να διαρκέσει ακόμα και μερικές μέρες. δ. Εάν μια ασθένεια έχει εξαπλωθεί σε όλο τον κόσμο, τότε έχουμε μια επιδημία.
|
|
1. Όταν κάποιος ασθενεί, συνήθως τα εμφανίζει. 2. Από τους πρώτους επιστήμονες που απέδειξαν τη μικροβιακή φύση ορισμένων ασθενειών. 3. Ο χρόνος που μεσολαβεί μεταξύ της μόλυνσης και της εμφάνισης των πρώτων συμπτωμάτων μιας ασθένειας. 4. Η αναγνώριση από τον γιατρό της ασθένειας από την οποία πάσχουμε. 5. Έτσι λέγεται ένας μικροοργανισμός που μας προκαλεί ασθένεια. 6. Μια ασθένεια που είναι εξαπλωμένη σε όλο τον κόσμο. 7. Και μέσω αυτού μεταδίδονται ορισμένες ασθένειες. (στην ονομαστική) 8. Η περίπτωση κατά την οποία μια ασθένεια έχει προσβάλει ένα μεγάλο αριθμό ατόμων. 9. Περιβαλλοντικοί παράγοντες που μπορεί να διαταράξουν την ομοιόστασή μας. 10. Σε αυτόν οδηγούμαστε αν συμβεί παρατεταμένη διαταραχή της ομοιόστασης. (στην ονομαστική)  Μικρές έρευνες και εργασίες
|